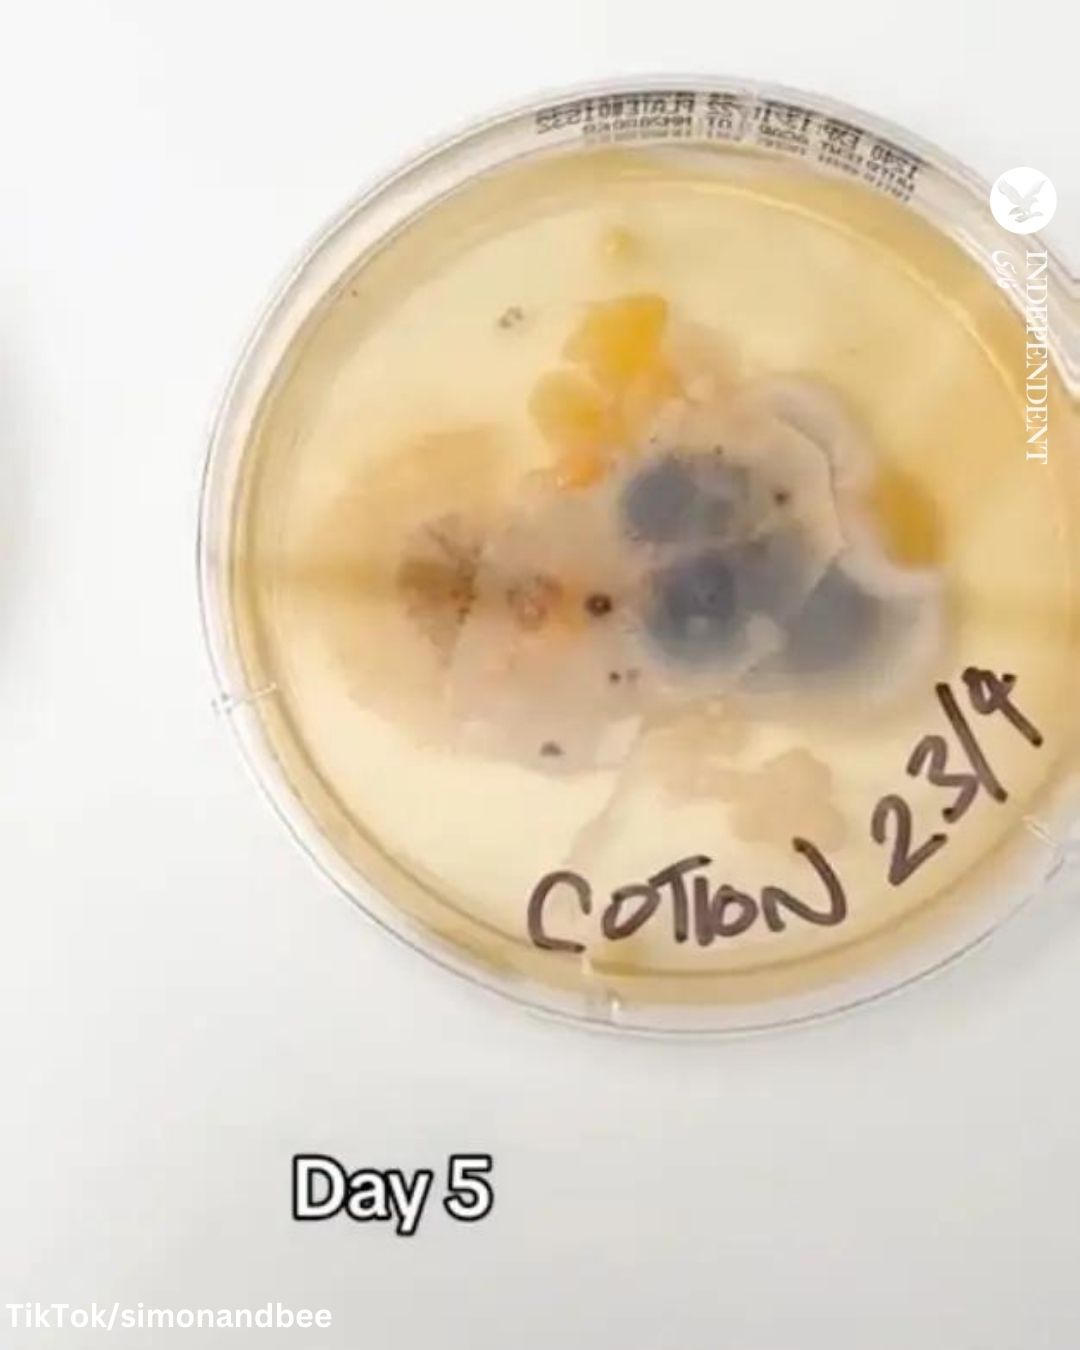

بر اساس گزارشی که اخیرا وبسایت «امریاسلیپ» (Amerisleep) منتشر کرده است، یک روبالشی تنها یک هفته پس از شستشو، میتواند میزبان سه میلیون باکتری باشد که حدود ۱۷ هزار برابر بیشتر از میانگین باکتری است که روی صندلی توالت فرنگی وجود دارد.
این تحقیق همچنین تمیزی تشک، ملحفهها و روبالشیها را بررسی کرده و عوامل بیماریزای بالقوهای که در ملحفهها وجود دارند را تجزیهوتحلیل کرده است.
ترکیبات حساسیتزا، انواع قارچ و پوست مرده در کنار کنه و موجودات میکروسکوپی که روی سلولهای پوست جداشده از بدن وجود دارند، ازجمله ذرات آلودهایاند که نمیخواهید شبها با آنها خلوت کنید.
کارشناسان همواره هشدار میدهند که روبالشیها باید بهطور منظم و بیش از یکبار در هفته تعویض شوند.
دکتر هدلی کینگ در گفتوگو با «ول اند گود» (Well+Good) به این نکته اشاره کرد که هنگامی که به رختخواب میروید، ملحفههای خود را با سلولهای مرده پوست (حدود ۵۰ میلیون در روز)، عرق، آرایش، لوسیون، مو و هر چیز دیگری که در طول روز به شما چسبیده است، ازجمله گرده گل، موی حیوانات خانگی تا کپک قارچی و ذرات خاک و باکتری و ویروس، آلوده میکنید.
دکتر هدلی ادامه داد که کنه از عرق و سلولهای مرده پوست تغذیه میکند و زمانی که آنها را به رختخواب میبرید، به تکثیر آنها کمک میکنید.
یکی از کاربران تیک تاک نیز اخیرا یک گزارش تصویری از تجمع باکتریهای روی روبالشی در این پلتفرم منتشر کرده است.
این مشاهدات پس از سالها تحقیق بر روی ملحفهها صورت میگیرد.
کاربر @simonandbee برای بازاریابی روبالشیهای حاوی نقره و ظاهرا ضدآکنه یک نشان تجاری، گوشهای از یک روبالشی معمولی را برید و آن را در ظرف آزمایشی قرار داد تا باکتریها و قارچها را در طول زمان نشان دهد.
بر اساس گزارش این کاربر، تنها پنج روز بعد، باکتریها بهسرعت روی تکه روبالشی نشسته تشکیل شدند.
درواقع، مطالعات گذشته نشان داده بود که باکتریهایی که عامل بیماریاند روی ملحفههای نشسته زندگی میکنند.
باوجود هشدارهای پزشکان مبنی بر تعویض هرچند روز یکبار روبالشی و هر هفته ملحفهها، برخی از افراد یک ماه یا بیشتر برای شستن ملحفههای خود صبر میکنند.
نظرسنجی موسسه گالوپ در بریتانیا نشان داد که تقریبا نیمی از مردان هر چهار ماه یک بار محلفههای خود را تعویض میکنند.